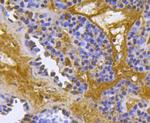
BMPR1A Antibody in Immunohistochemistry (Paraffin) (IHC (P))

Search
Huabio
BMPR1A Polyclonal Antibody
{{$productOrderCtrl.translations['antibody.pdp.commerceCard.promotion.promotions']}}
{{$productOrderCtrl.translations['antibody.pdp.commerceCard.promotion.viewpromo']}}
{{$productOrderCtrl.translations['antibody.pdp.commerceCard.promotion.promocode']}}: {{promo.promoCode}} {{promo.promoTitle}} {{promo.promoDescription}}. {{$productOrderCtrl.translations['antibody.pdp.commerceCard.promotion.learnmore']}}
产品信息
R1510-1
种属反应
宿主/亚型
分类
类型
抗原
偶联物
形式
浓度
规格
纯化类型
保存液
内含物
保存条件
运输条件
靶标信息
BMPR1A is a Type I member of the TGF beta receptor superfamily of transmembrane ser/thr kinases which phosphorylates intracellular SMADs in response to bone morphogenic proteins. These receptors are also closely related to the activin receptors, ACVR1 and ACVR2. The ligands of these receptors are members of the TGF-beta superfamily. TGF-betas and activins transduce their signals through the formation of heteromeric complexes with 2 different types of serine (threonine) kinase receptors: type I receptors of about 50-55 kD and type II receptors of about 70-80 kD. Type II receptors bind ligands in the absence of type I receptors, but they require their respective type I receptors for signaling, whereas type I receptors require their respective type II receptors for ligand binding.
仅用于科研。不用于诊断过程。未经明确授权不得转售。
篇参考文献 (0)
生物信息学
蛋白别名: activin A receptor, type II-like kinase 3; Activin receptor-like kinase 3; ALK-3; BMP type-1A receptor; BMP-2/BMP-4 receptor; BMPR-1A; BMPRIA; Bone morphogenetic protein 4 receptor; Bone morphogenetic protein receptor type-1A; bone morphogenetic protein receptor, type 1A; bone morphogenetic protein receptor, type IA; CD292; Serine/threonine-protein kinase receptor R5; SKR5; unnamed protein product
基因别名: 10q23del; 1110037I22Rik; ACVRLK3; ALK-3; ALK3; AU045487; Bmpr; BMPR-1A; BMPR-IA; BMPR1A; CD292; SKR5
UniProt ID: (Human) P36894, (Rat) Q78EA7, (Mouse) P36895
Entrez Gene ID: (Human) 657, (Rat) 81507, (Mouse) 12166